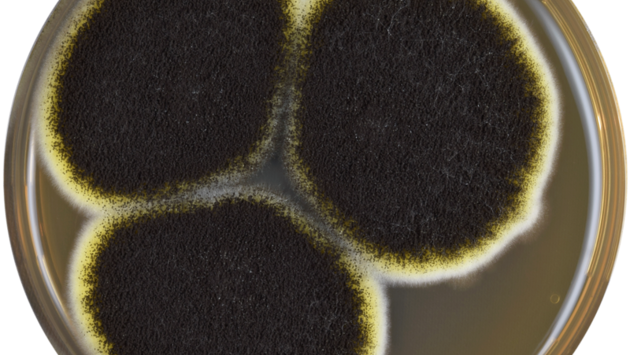

Китайские ученые из Нанкинского медицинского университета обнаружили новую грибковую инфекцию, опасную для человека. Ее вызывает грибок под названием Rhodosporidiobolus fluvialis (R. fluvialis). Исследование опубликовано в научном журнале Nature Microbiology (NatMicrobiol).
Выводы команды основаны на изучения 27,1 тыс. штаммов грибков, собранных по всему Китаю с 2009 по 2021 год. Из этого многообразия только R. fluvialis никогда прежде не встречался у человека.
Микроорганизм нашли у двух не связанных между собой пациентов, проходивших лечение в 2013 и 2016 годах. Оба человека на момент заражения находились в преклонном возрасте (61 год и 85 лет). Впоследствии они ушли из жизни. В отчете не указано, способствовала ли грибковая инфекция летальным исходам или же больные были заражены ею в то время.
Как показали эксперименты, новый патоген может становиться сверхзаразным под действием температуры человеческого тела.
Учены заразили иммунодефицитных мышей R. fluvialis и обнаружили, что некоторые из грибковых клеток быстро эволюционировали, чтобы расти более агрессивно. При 37°C микроорганизмы мутировали в 21 раз быстрее, чем при комнатной температуре.
Тепло также повысило вероятность того, что R. fluvialis приобретет лекарственную устойчивость. При воздействии противогрибкового препарата амфотерицина B грибок быстрее развивал к нему устойчивость при 37°C.
Исследователи отметили, что опасные мутации грибка могут быть связаны с глобальными изменениями климата.